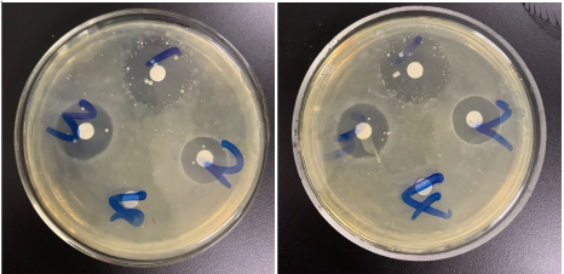
本次试验针对大肠杆菌引起的包心包肝之类的疾病所采取的病料.
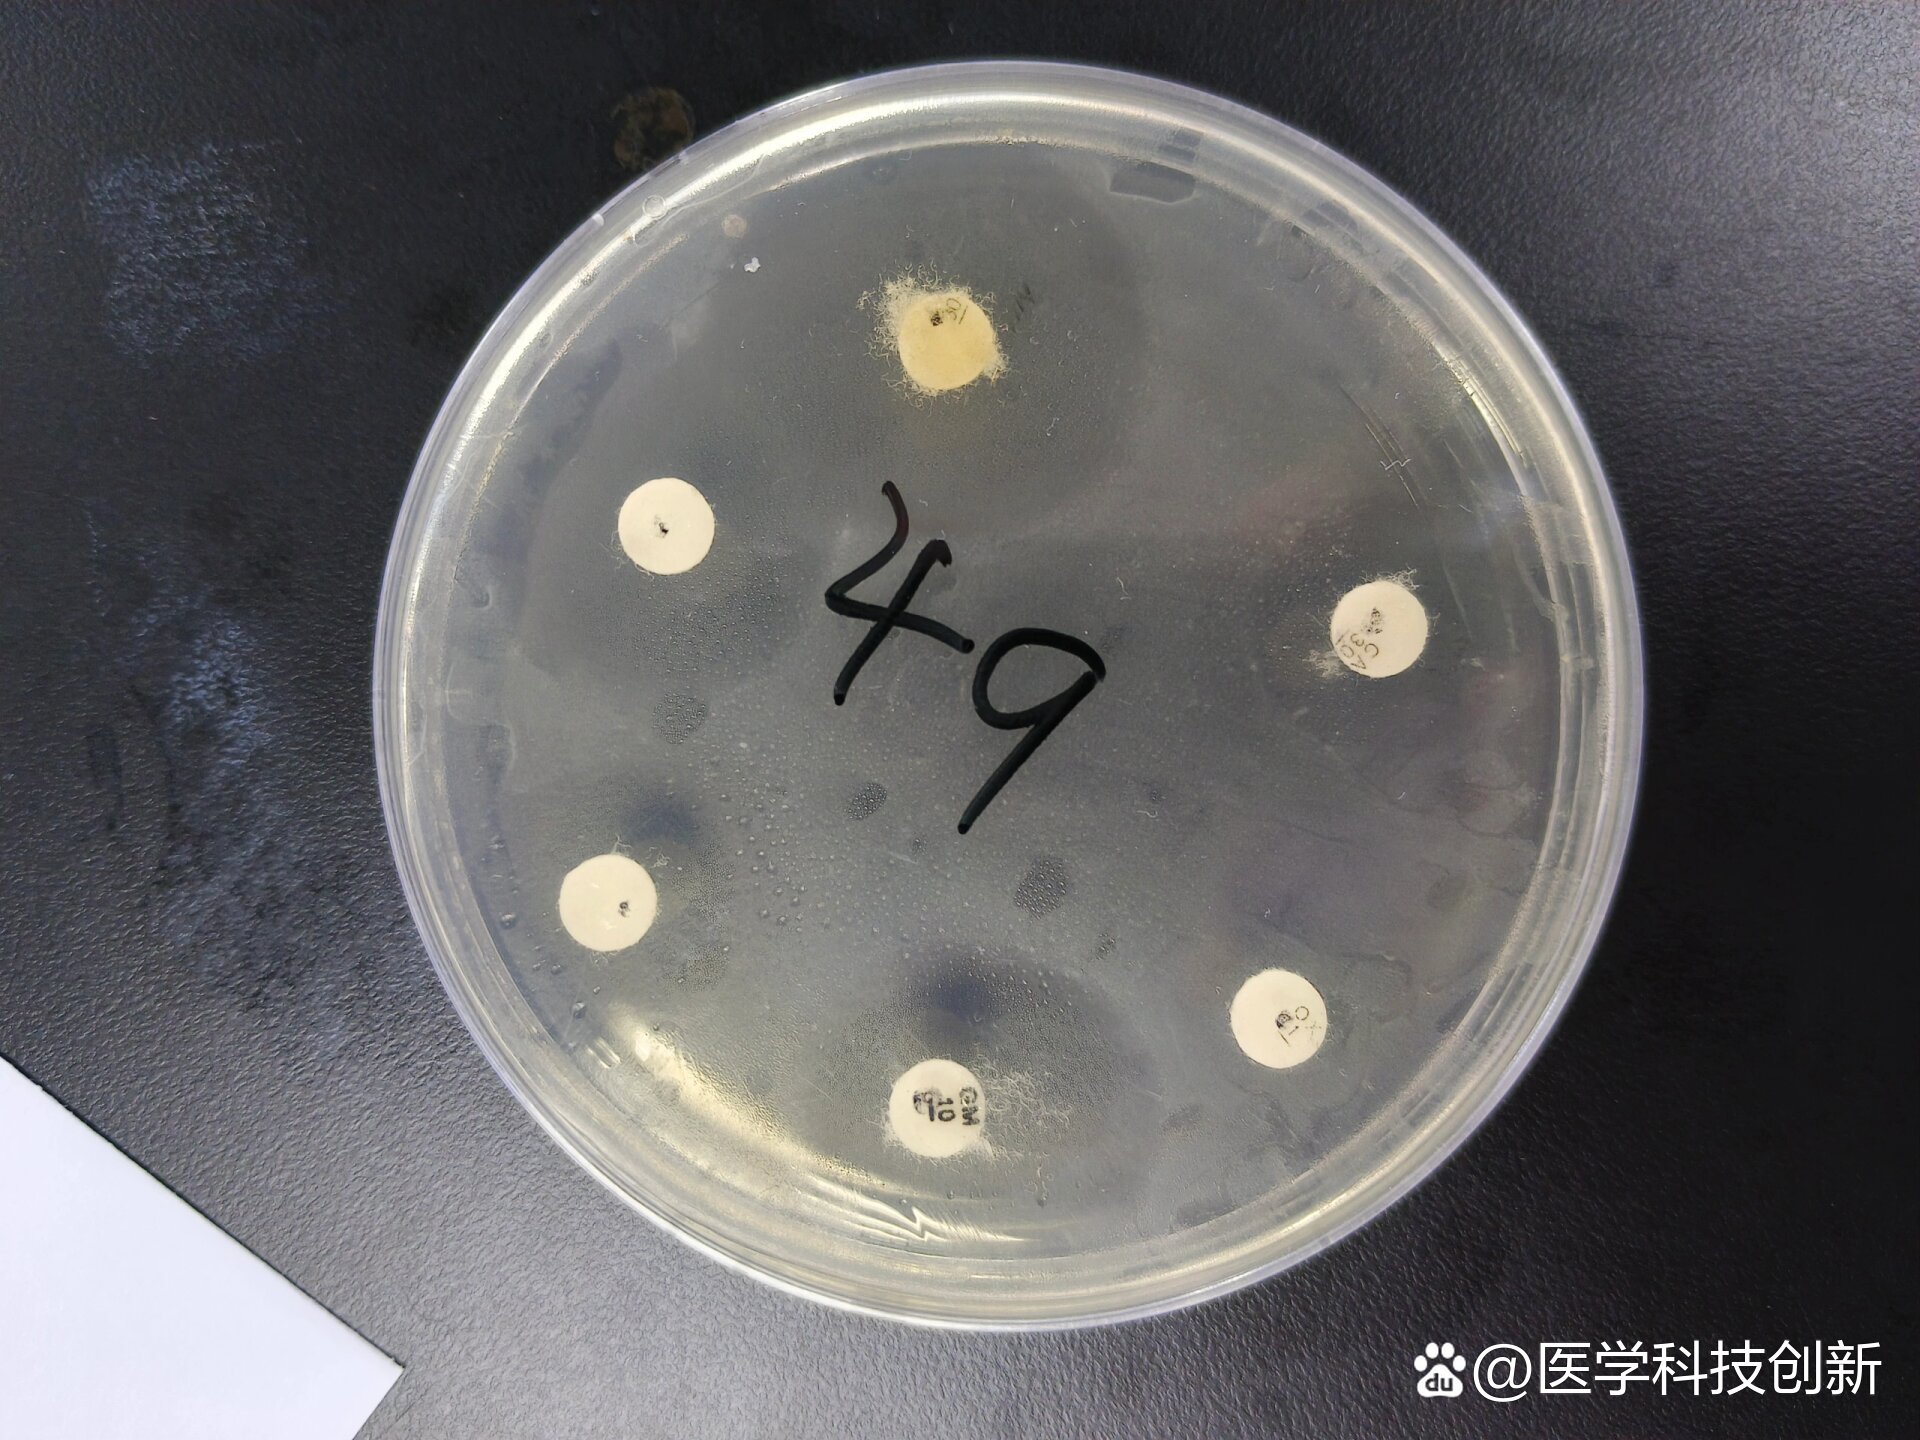
大肠杆菌的药敏试验
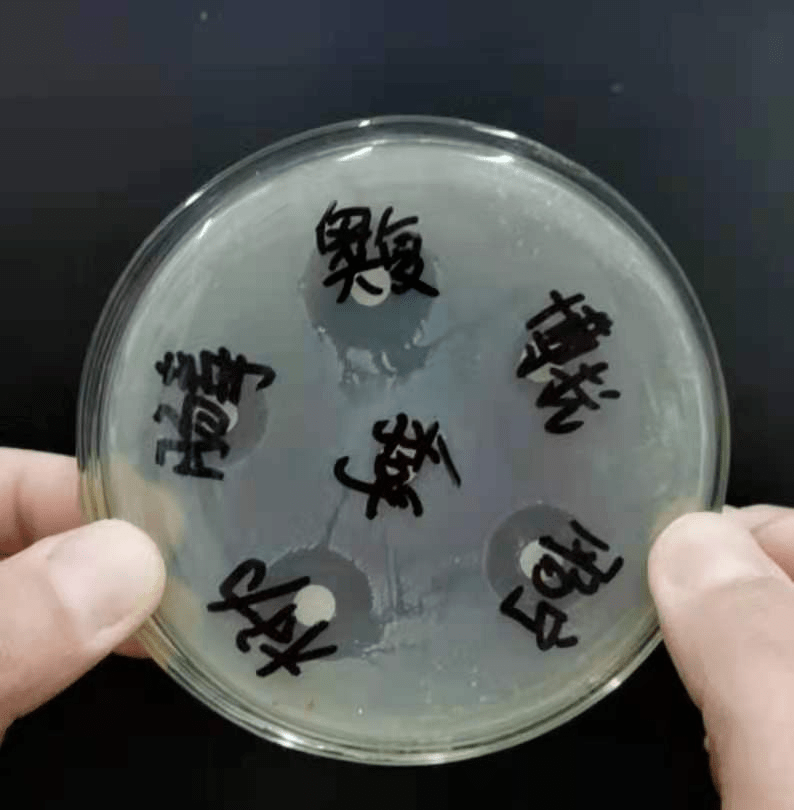
药敏试验的重要性

大肠杆菌药敏试验图片

本次试验针对大肠杆菌引起的包心包肝之类的疾病所采取的病料.
图片尺寸564x274
药敏试验
图片尺寸1052x780
nor大概是多少?
图片尺寸533x400
药敏实验
图片尺寸2592x1944
怀疑是转群应激和冷应激激发鸡群呼吸道病,并继发大肠杆菌感染.
图片尺寸713x593
做不同细菌的药敏试验可选择不同的培养基,如做大肠杆菌的药敏试验可
图片尺寸500x300
用药方案:独清(腺胃型)配合药敏试验高敏药物用药四天后回访:用药当天
图片尺寸1080x810
本次试验针对大肠杆菌引起的包心包肝之类的疾病所采取的病料.
图片尺寸540x290
药敏实验
图片尺寸2592x1944
二,药敏试验没有做的药物?1,可能是天然耐药.
图片尺寸690x920
大肠杆菌的药敏试验
图片尺寸1920x1440
细菌分离结果镜检为大肠杆菌药敏实验结果注:抑菌圈直径大于20mm者
图片尺寸530x603
药敏试验的重要性
图片尺寸794x810
图-5 链球菌的药敏试验表-4 海豚链链球菌mp002的药敏试验 单位:mm
图片尺寸660x336
61药敏试验(金葡菌代表的革兰阳性和大肠杆菌代表的革兰阴性)61
图片尺寸1080x810
镇岭下村温州国敏畜牧养殖场,就鸽子鸽瘟,禽流感,大肠杆菌病等疫病
图片尺寸800x554
晋龙病理化验室--药敏实验
图片尺寸750x1000
药敏试验
图片尺寸480x370
我做的药敏
图片尺寸2560x1920
用自制药敏试纸进行肉鸡大肠杆菌病的药敏试验
图片尺寸419x207